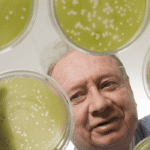
090226 Van Etten 167 e1414627907773 فيروس يؤدي إلى نقص الأداء الإدراكي لدى البشر مجلة نقطة العلمية

وفقاً لاستقصاء شامل جديد تم نشره في مجلة (PLOS Medicine)، فإن معدل جلسات غسيل الكلى في مراحلها الأخيرة التي تخضع لها النساء، أقل من معدل الجلسات التي يقوم بها الرجال، حيث تم إجراء هذا الاستقصاء في إطار البحث لإيجاد الفروق بين الجنسين فيما يخص الأمور العلاجية، وقد أظهرت الدراسة التي أجراها (مانفريد هيكينج) مع (فريدريش بورت) وزملاؤه من بحوث أربور التعاونية للصحة في آن أربور، في ميشيغان، أن النتائج تدعو إلى دراسة أكثر تفصيلاً للأسباب الكامنة وراء الفروق بين الجنسين خاصة في نهاية مرحلة علاج الفشل الكلوي.
غالباً ما تتطور حالة الأشخاص الذين يعانون من مرض الكلى المزمن إلى المرحلة النهائية للفشل الكلوي، حيث تتم معالجتهم من خلال غسيل الكلى المنتظم (وهي عملية يتم فيها تنقية الدم عن طريق تمريره من خلال جهاز الترشيح “الديال”)، أو عن طريق زرع الكلى، لذلك قام الباحثون بإجراء تحليل مبني على الفروق التي توجد بشكل خاص بين أفراد الجنسين الذين يعانون من الفشل الكلوي في مرحلته النهائية، وكان الهدف من التحليل معرفة الاختلافات العلاجية وسبل تحسين الرعاية الصحية، بناء على جنس المريض، باستخدام دراسة نتائج غسيل الكلى والأنماط المتبعة لهذا الغرض والتي تدعى (DOPPS)، وبذلك تكون (DOPPS) هي عبارة عن دراسة جماعية محتملة تعتمد على التحقيق في خصائص المرض، وعلاجه، ونتائجه عند الأشخاص البالغين الذين يخضعون لغسيل الكلى في أحد مراكز غسيل الكلى الموجودة في 19 بلداً.
تمت دراسة 206,374 مريضاً ينتمون إلى 12 بلداً من أصل 19 بلداً تمتلك مراكز لغسيل الكلى، وذلك لتحديد إمكانية وجود أي اختلافات تعتمد على الجنس تتعلق بمعدل انتشار غسيل الكلى وطريقة تطبيقه ومقدار الوفيات من الذكور والإناث بين المرضى الذين يخضعون لغسيل الكلى، بعد ذلك تمت مقارنة نتائج هذه الدراسة مع قاعدة بيانات الوفيات البشرية الصادرة عن منظمة الصحة العالمية، والتي توفر بيانات تفصيلية عن السكان والوفيات لكل البلدان، وقد بينت النتائج أن معدل بقاء النساء على قيد الحياة بعد غسيل الكلى مساوٍ تقريباً لمعدل الرجال، إلا أنه تبين أن النساء لا يتلقون علاج غسيل الكلى في وقت مبكر من تشخيص المرض، على عكس الرجال الذين يتلقون جلسات غسيل كلى أكثر كونهم يتلقون العلاج في وقت مبكر من المرض، وهذا قد يؤدي إلى ارتفاع معدل الوفيات قبل الحصول على العلاج بين النساء، ولكن عموماً، أظهرت هذه الدراسة أن عدد الرجال الذين يخضعون لغسيل الكلى كان أكبر من النساء (59٪ من الرجال مقابل 41٪من النساء)، في الوقت الذي كانت فيه تقارير سابقة قد بينت أن مرض الكلى المزمن يميل إلى أن يكون أكثر شيوعاً لدى النساء بشكل عام، والجدير بالذكر أن الرجال كانوا أيضاً المستفيدين بصورة أكبر من عملية زرع الكلى مقارنة بالنساء.
بينت نتائج هذه الدراسة أن معدل بقاء النساء على قيد الحياة قد انخفض خلال السنوات الماضية، حتى أصبح مساوياً لعدد الرجال، كما أن عدد النساء اللواتي يخضعن لعلاج الفشل الكلوي في مراحله الأخيرة أصبح أقل من عدد الرجال، ولكن من ناحية ثانية فإن بعض هذه الفروق المحددة بين الجنسين والتي وجدت في علاج غسيل الكلى قد تكون مرتبطة ببيولوجيا الجسم، كما يمكن أن تتعلق أيضاً بعوامل أخرى مثل الرعاية والتوعية الطبية التي تقدم للمرضى الذين يعانون من مرض الكلى مزمن.